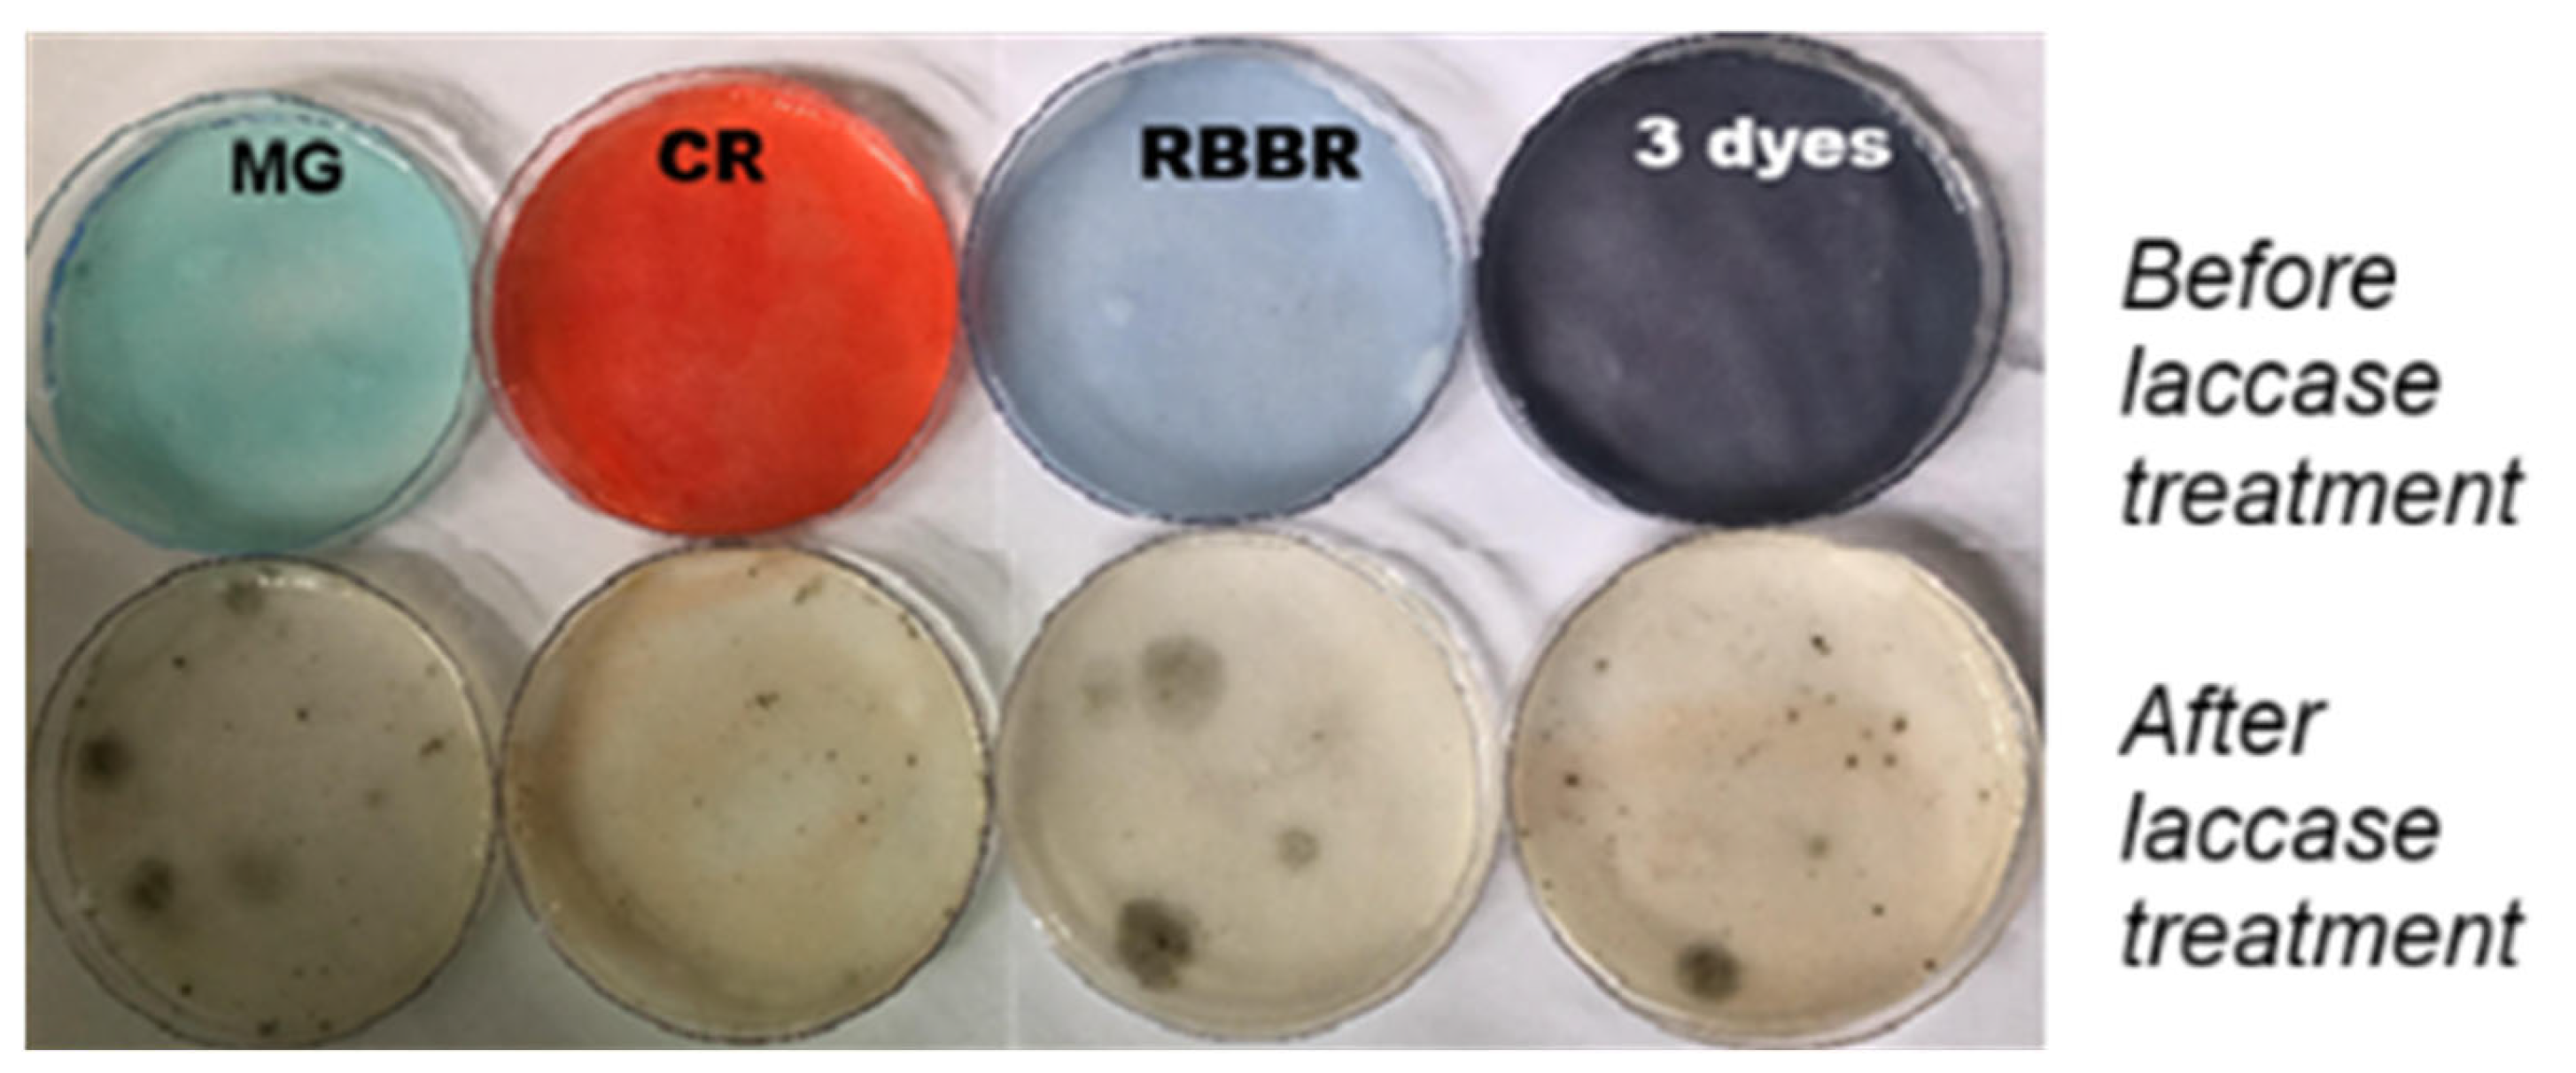
Reactions 06 00053 g007 Reactions 06 00053 g007

Decolorization and Detoxification of Synthetic Dyes by Trametes versicolor Laccase Under Salt Stress Conditions
Abstract
1. Introduction
2. Materials and Methods
2.1. Materials
2.2. Microorganism and Laccase Production
2.3. Laccase Activity Determination
2.4. Effects of Na2SO4 and NaCl on Laccase Kinetic Parameters
2.5. Use of the Laccase for Decolorizing Synthetic Dyes in the Absence and Presence of Salts (Na2SO4 and NaCl)
2.6. Infrared Spectroscopy
2.7. Ecotoxicity Analysis of the Dyes Before and After Laccase Treatment
2.7.1. Phytotoxicity Assay (Lactuca sativa)
2.7.2. Fungal Growth Inhibition Assay (Aspergillus awamori)
3. Results
3.1. Evaluation of T. versicolor Laccase Activity in the Presence of Na2SO4 and NaCl
3.2. Decolorization of Synthetic Dyes by Trametes Versicolor Laccase: The Effects of Salts
3.3. Fourier Transform Infrared Spectroscopy
3.4. Toxicity Studies
4. Discussion
Author Contributions
Funding
Data Availability Statement
Conflicts of Interest
References
- Oladoye, P.O.; Bamigboye, M.O.; Ogunbiyi, O.D.; Akano, M.T. Toxicity and decontamination strategies of Congo red dye. Groundw. Sustain. Dev. 2022, 19, 100844. [Google Scholar] [CrossRef]
- Poopal, R.K.; Ashwini, R.; Ramesh, M.; Li, B.; Ren, Z. Triphenylmethane dye (C52H54N4O12) is potentially a hazardous substance in edible freshwater fish at trace level: Toxicity, hematology, biochemistry, antioxidants, and molecular docking evaluation study. Environ. Sci. Pollut. Res. 2023, 30, 28759–28779. [Google Scholar] [CrossRef]
- Aracagök, Y.D. Biosorption of Remazol Brilliant Blue R dye onto chemically modified and unmodified Yarrowia lipolytica biomass. Arch. Microbiol. 2022, 204, 128. [Google Scholar] [CrossRef]
- Nagray Chaurasia, P.K.; Bharati, S.L.; Sharma, N. Degradation of dyes by fungi: An overview on recent updates. Microbes 2025, 6, 100232. [Google Scholar] [CrossRef]
- Benkhaya, S.; M’rabet, S.; El Harfi, A. A review on classifications, recent synthesis and applications of textile dyes. Inorg. Chem. Commun. 2020, 115, 107891. [Google Scholar] [CrossRef]
- Yaseen, D.A.; Scholz, M. Textile dye wastewater characteristics and constituents of synthetic effluents: A critical review. Int. J. Environ. Sci. Technol. 2019, 16, 1193–1226. [Google Scholar] [CrossRef]
- Brito, M.J.P.; Veloso, C.M.; Santos, L.S.; Bonomo, R.C.F.; Fontan, R.D.C.I. Adsorption of the textile dye Dianix® royal blue CC onto carbons obtained from yellow mombin fruit stones and activated with KOH and H3PO4: Kinetics, adsorption equilibrium and thermodynamic studies. Powder Technol. 2018, 339, 334–343. [Google Scholar] [CrossRef]
- Qadri, R.; Faiq, M.A. Freshwater pollution: Effects on aquatic life and human health. In Fresh Water Pollution Dynamics and Remediation; Springer: Singapore, 2019; pp. 15–26. [Google Scholar] [CrossRef]
- Abhisek, K.; Vhatkar, S.; Mathew, H.T.; Singh, P.; Oraon, R. A critical review on the challenges and techno-economic assessment of dyes removal technologies from waste water. Discov. Chem. 2025, 2, 41. [Google Scholar] [CrossRef]
- Alegbeleye, O.O.; Opeolu, B.O.; Jackson, V.A. Polycyclic aromatic hydrocarbons: A critical review of environmental occurrence and bioremediation. Environ. Manag. 2017, 60, 758–783. [Google Scholar] [CrossRef]
- Thathola, P.; Melchor-Martínez, E.M.; PAdhikari, P.; Martínez, S.A.H.; Pandey, A.; -Saldívar, R.P. Laccase-mediated degradation of emerging contaminants: Unveiling a sustainable solution. Environ. Sci. Adv. 2024, 3, 1500–1512. [Google Scholar] [CrossRef]
- Patel, D.; Singh, A.; Ambati, S.R.; Singh, R.S.; Sonwani, R.K. An overview of recent advances in treatment of complex dye-containing wastewater and its techno-economic assessment. J. Environ. Manag. 2024, 370, 122804. [Google Scholar] [CrossRef] [PubMed]
- Lin, S.; Wei, J.; Yang, B.; Zhang, M.; Zhuo, R. Bioremediation of organic pollutants by white rot fungal cytochrome P450: The role and mechanism of CYP450 in biodegradation. Chemosphere 2022, 301, 134776. [Google Scholar] [CrossRef] [PubMed]
- Kesari, K.K.; Soni, R.; Jamal, Q.M.S.; Tripathi, P.; Lal, J.A.; Jha, N.K.; Siddiqui, M.H.; Kumar, P.; Tripathi, V.; Ruokolainen, J. Wastewater treatment and reuse: A review of its applications and health implications. Water Air Soil Pollut. 2021, 232, 208. [Google Scholar] [CrossRef]
- Zhuo, R.; Fan, F. A comprehensive insight into the application of white rot fungi and their lignocellulolytic enzymes in the removal of organic pollutants. Sci. Total Environ. 2021, 778, 146132. [Google Scholar] [CrossRef] [PubMed]
- Chen, L.; Zhang, X.; Zhang, M.; Zhu, Y.; Zhuo, R. Removal of heavy-metal pollutants by white rot fungi: Mechanisms, achievements, and perspectives. J. Clean. Prod. 2022, 354, 131681. [Google Scholar] [CrossRef]
- Arregui, L.; Ayala, M.; Gómez-Gil, X. Laccases: Structure, function, and potential application in water bioremediation. Microb. Cell Factories 2019, 18, 200. [Google Scholar] [CrossRef]
- Xu, L.; Sun, K.; Wang, F.; Zhao, L.; Hu, J.; Ma, H.; Ding, Z. Laccase production by Trametes versicolor in solid-state fermentation using tea residues as substrate and its application in dye decolorization. J. Environ. Manag. 2020, 270, 110904. [Google Scholar] [CrossRef]
- Aysha, T.S.; Ahmed, N.S.; El-Sedik, M.S.; Youssef, Y.A.; El-Shishtawy, R.M. Eco-friendly salt/alkali-free exhaustion dyeing of cotton fabric with reactive dyes. Sci. Rep. 2022, 12, 22339. [Google Scholar] [CrossRef]
- Acharya, S.; Abidi, N.; Rajbhandari, R.; Meulewaeter, F. Chemical cationization of cotton fabric for improved dye uptake. Cellulose 2014, 21, 4693–4706. [Google Scholar] [CrossRef]
- Champagne, P.P.; Nesheim, M.E.; Ramsay, J.A. A mechanism for NaCl inhibition of Reactive Blue 19 decolorization and ABTS oxidation by laccase. Appl. Microbiol. Biotechnol. 2013, 97, 6263–6269. [Google Scholar] [CrossRef]
- Struch, M.; Krahe, N.K.; Linke, D.; Mokoonlall, A.; Hinrichs, J.; Berger, R.G. Dose dependent effects of a milk ion tolerant laccase on yoghurt gel structure. LWT 2016, 65, 1144–1152. [Google Scholar] [CrossRef]
- Vogel, H.J. A convenient growth medium for Neurospora (Medium N). Microbial Genet. Bulls 1956, 13, 42–43. [Google Scholar]
- Laemmli, U. Cleavage of Structural Proteins during the Assembly of the Head of Bacteriophage T4. Nature 1970, 227, 680–685. [Google Scholar] [CrossRef] [PubMed]
- de Freitas, E.N.; Bubna, G.A.; Brugnari, T.; Kato, C.G.; Nolli, M.; Rauen, T.G.; Moreira, R.F.P.M.; Peralta, R.A.; Bracht, A.; de Souza, C.G.M.; et al. Removal of bisphenol a by laccases from Pleurotus ostreatus and Pleurotus pulmonarius and evaluation of ecotoxicity of degradation products. Chem. Eng. J. 2017, 330, 1361–1369. [Google Scholar] [CrossRef]
- Backes, E.; Kato, C.G.; da Silva, T.B.; Uber, T.M.; Pasquarelli, D.L.; Bracht, A.; Peralta, R.M. Production of fungal laccase on pineapple waste and application in detoxification of malachite green. J. Environ. Sci. Health Part B 2022, 57, 90–101. [Google Scholar] [CrossRef]
- Mota, T.R.; Kato, C.G.; Peralta, R.A.; Bracht, A.; de Morais, G.R.; Baesso, M.L.; de Souza, C.G.; Peralta, R.M. Decolourization of Congo red by Ganoderma lucidum laccase: Evaluation of degradation products and toxicity. Water Air Soil Pollut. 2015, 226, 351–362. [Google Scholar] [CrossRef]
- Akaike, H. A new look at the statistical model identification. IEEE Trans. Autom. Control 1974, 19, 716–723. [Google Scholar] [CrossRef]
- Coelho-Moreira, J.S.; Brugnari, T.; Sá-Nakanishi, A.B.; Castoldi, R.; De Souza, C.G.; Bracht, A.; Peralta, R.M. Evaluation of diuron tolerance and biotransformation by the white-rot fungus Ganoderma lucidum. Fungal Biol. 2018, 122, 471–478. [Google Scholar] [CrossRef]
- Plowman, K.M. Enzyme Kinetics; McGraw-Hill Book Company: New York, NY, USA, 1972. [Google Scholar]
- Cornish-Bowden, A. Fundamentals of Enzyme Kinetics; Wiley-VCH Verlag & Co. KgaA: Weinheim, Germany, 2012. [Google Scholar]
- Carrascal-Hernández, D.C.; Orozco-Beltrán, E.J.; Insuasty, D.; Márquez, E.; Grande-Tovar, C.D. Systematic evaluation of biodegradation of dyes by microorganisms: Efficient species, physicochemical factors, and enzymatic systems. Int. J. Mol. Sci. 2025, 26, 7973. [Google Scholar] [CrossRef]
- Wang, J.; Wang, S. Reactive species in advanced oxidation processes: Formation, identification and reaction mechanism. Chem. Eng. J. 2020, 401, 126158. [Google Scholar] [CrossRef]
- Parida, V.K.; Singh, N.; Priyadarshini, M.; Kumari, P.; Datta, D.; Tambi, A. Insights into the synthetic dye contamination in textile wastewater: Impacts on aquatic ecosystems and human health, and eco-friendly remediation strategies for environmental sustainability. J. Ind. Eng. Chem. 2025, 150, 247–264. [Google Scholar] [CrossRef]
- Abadulla, E.; Tzanov, T.; Costa, S.; Robra, K.H.; Cavaco-Paulo, A.; Gübitz, G.M. Decolorization and Detoxification of Textile Dyes with a Laccase from Trametes hirsuta. Appl. Environ. Microbiol. 2000, 66, 3357–3362. [Google Scholar] [CrossRef] [PubMed]
- Iark, D.; Buzzo, A.J.; Garcia, J.A.A.; Corrêa, V.G.; Helm, C.V.; Corrêa, R.C.G.; Peralta, R.A.; Moreira, R.F.P.M.; Bracht, A.; Peralta, R.M. Enzymatic degradation and detoxification of azo dye Congo red by a new laccase from Oudemansiella canarii. Bioresour. Technol. 2019, 294, 121768. [Google Scholar] [CrossRef] [PubMed]
- Li, Q.; Feng, Y.; Zhuang, S.; Kang, L.; Yang, Y. Decolorization and Detoxification of Azo and Triphenylmethane Dyes by Crude Laccase Extracted from Pleurotus ostreatus yang1. Int. J. Mol. Sci. 2025, 26, 8363. [Google Scholar] [CrossRef]
- Paraschiv, G.; Ferdes, M.; Ionescu, M.; Moiceanu, G.; Zabava, B.S.; Dinca, M.N. Laccases—Versatile Enzymes Used to Reduce Environmental Pollution. Energies 2022, 15, 1835. [Google Scholar] [CrossRef]
- Jeyabalan, J.; Alfarhan, A.; Alharbi, S. A review on the laccase-assisted decolourization of dyes: Recent trends and research progress. J. Taiwan Inst. Chem. Eng. 2023, 150, 105081. [Google Scholar] [CrossRef]
- Zilly, A.; da Silva Coelho-Moreira, J.; Bracht, A.; De Souza, C.G.M.; Carvajal, A.E.; Koehnlein, E.A.; Peralta, R.M. Influence of NaCl and Na2SO4 on the kinetics and dye decolorization ability of crude laccase from Ganoderma lucidum. Int. Biodeterior. Biodegrad. 2011, 65, 340–344. [Google Scholar] [CrossRef]
- Enaud, E.; Trovaslet, M.; Naveau, F.; Decristoforo, A.; Bizet, S.; Vanhulle, S.; Jolivalt, C. Laccase chloride inhibition reduction by an anthraquinonic substrate. Enz. Microb. Technol. 2011, 49, 517–525. [Google Scholar] [CrossRef]
- Trovaslet, M.; Enaud, E.; Guiavarc’h, Y.; Corbisier, A.M.; Vanhulle, S. Potential of a Pycnoporus sanguineus laccase in bioremediation of wastewater and kinetic activation in the presence of an anthraquinonic acid dye. Enz. Microb. Technol. 2007, 41, 368–376. [Google Scholar] [CrossRef]
- Raseda, N.; Hong, S.; Kwon, O.Y.; Ryu, K. Kinetic evidence for the interactive inhibition of laccase from Trametes versicolor by pH and chloride. J. Microbiol. Biotechnol. 2014, 24, 1673–1678. [Google Scholar] [CrossRef]
- Cheute, V.M.S.; Backes, E.; Pateis, V.d.O.; de Oliveira Junior, V.A.; Uber, T.M.; dos Santos Filho, J.R.; dos Santos, L.F.O.; Castoldi, R.; de Souza, C.G.M.; Polonio, J.C.; et al. Optimization of Immobilization, Characterization, and Environmental Applications of Laccases from Pycnoporus sanguineus UEM-20. Processes 2025, 13, 1800. [Google Scholar] [CrossRef]
- Baici, A. Kinetics of Enzyme-Modifier Interactions. In The General Modifier Mechanism; Springer: Berlin, Germany, 2015; pp. 65–102. [Google Scholar] [CrossRef]
- Botts, J.; Morales, M. Analytical Description of the Effects of Modifiers and of Enzyme Multivalency upon the Steady State Catalyzed Reaction Rate. Trans. Faraday Soc. 1953, 49, 696–707. [Google Scholar] [CrossRef]
- Backes, E.; Alnoch, R.C.; Contato, A.G.; Cstldi, R.; de Souza, C.G.M.; Kato, C.G.; Peralta, R.A.; Moreira, R.F.P.M.; Polizeli, M.L.T.M.; Bracht, A.; et al. Properties and kinetic behavior of free and immobilized laccase from Oudemansiella canarii: Emphasis on the effects of NaCl and Na2SO4 on catalytic activities. Int. J. Biol. Macromol. 2024, 281, 136565. [Google Scholar] [CrossRef] [PubMed]
- Chakravarthi, B.; Mathakala, V.; Palempalli, U.M.D. Degradation and Detoxification of Congo Red Azo Dye by Immobilized Laccase of Streptomyces sviceus. J. Pure Appl. Microbiol. 2021, 15, 864–876. [Google Scholar] [CrossRef]
- Aounallah, F.; Hkiri, N.; Fouzai, K.; Elaoud, A.; Aved, L.; Asses, N. Biodegradation Pathway of Congo Red azo dye by Geotrichum candidum and Toxicity Assessment of Metabolites. Catal. Lett. 2024, 154, 6064–6079. [Google Scholar] [CrossRef]
- Asses, N.; Ayed, L.; Hkiri, N.; Hamdi, M. Congo Red Decolorization and Detoxification by Aspergillus niger: Removal Mechanisms and Dye Degradation Pathway. BioMed Res. Int. 2018, 6, 3049686. [Google Scholar] [CrossRef]
- Pandey, D.; Daverey, A.; Dutta, K.; Arunachalam, K. Bioremoval of toxic malachite green from water through simultaneous decolorization and degradation using laccase immobilized biochar. Chemosphere 2022, 297, 134126. [Google Scholar] [CrossRef]
- Arunprasath, T.; Sudalai, S.; Meenatchi, R.; Jeyavishnu, K.; Arumugam, A. Biodegradation of triphenylmethane dye malachite green by a newly isolated fungus strain. Biocatal. Agric. Biotechnol. 2019, 17, 672–679. [Google Scholar] [CrossRef]
- Barapatre, A.; Aadil, K.R.; Jha, H. Biodegradation of Malachite Green by the Ligninolytic Fungus Aspergillus flavus. Clean Soil Air Water 2017, 45, 1600045. [Google Scholar] [CrossRef]
- Yadav, A.; Yadav, P.; Sing, A.K.; Kumar, V.; Sonawane, V.C.; Markandeya Bharagava, R.N.; Raj, A. Decolourisation of textile dye by laccase: Process evaluation and assessment of its degradation bioproducts. Bioresour. Technol. 2021, 340, 125591. [Google Scholar] [CrossRef]
- Uber, T.M.; Buzzo, A.J.d.R.; Scaratti, G.; Amorim, S.M.; Helm, C.V.; Maciel, G.M.; Peralta, R.A.; Moreira, R.d.F.P.M.; Bracht, A. Comparative detoxification of Remazol Rrilliant Blue R by free and immobilized laccase of Oudemansiella canarii. Biocatal. Biotransformation 2020, 40, 17–28. [Google Scholar] [CrossRef]
- Cardullo, N.; Muccilli, V.; Tringali, C. Laccase-mediated synthesis of bioactive natural products and their analogues. RSC Chem. Biol. 2022, 3, 614–647. [Google Scholar] [CrossRef]
- Pasieczna-Patkowska, S.; Cichy, M.; Flieger, J. Application of Fourier transform infrared (FTIR) spectroscopy in characterization of green synthesized nanoparticles. Molecules 2025, 30, 684. [Google Scholar] [CrossRef]

| Kinetic Constants and Statistical Indicators | NaCl | Na2SO4 |
|---|---|---|
| Vmax (µmol/min) | 4.84 ± 0.05 | 4.85 ± 0.05 |
| KM (mM) | 0.0712 ± 0.0035 | 0.0686 ± 0.0037 |
| Ki1 (M) | 0.0364 ± 0.0036 | 0.788 ± 0.145 |
| Ki2 (M) | 0.234 ± 0.021 | 1.221 ± 0.077 |
| Model selection criterion | 5.858 | 4.939 |
| Correlation (r) | 0.998 | 0.997 |
| Sum of squared deviations | 0.133 | 0.207 |
| Dye | Affected Groups | Expected FTIR Changes | Reference |
|---|---|---|---|
| Congo red | –N=N –SO3H Aromatic C=C | Disappearance or decrease of N=N (~1580–1600); Reduced S=O (~1040–1180); new C=O (~1700) | [47,48,49,50] |
| Malachite green | –N(CH3)2 Aromatic C–H | Decrease in C–N (~1120–1250) and C–H (~2800–3000); new O–H (~3200–3600), C=O (~1700) | [26,51,52,53] |
| RBBR | –SO3−, C=O, Aromatic rings | Decrease in S=O (~1040–1190) and C=O (~1660–1700); loss of aromatic bands; new O–H, C=O | [54,55] |
| Fungal Laccase | Synthetic Dyes/ Salts Tested | Decolorization Efficiency | Detoxification | Reference |
|---|---|---|---|---|
| Ganoderma lucidum (crude laccase) | RBBR/NaCl and Na2SO4 | Complete decolorization with 1.0 M Na2SO4, ~50% with 0.1 M NaCl | ND | [40] |
| Trametes hirsuta (immobilized laccase) | Reactive Blue 19 (RB19), NaCl | 80% decolorization. | Up to 84% detoxification for RB19 | [35] |
| Trametes versicolor (purified laccase) | Reactive Blue 19/NaCl and Na2SO4 | Detailed mechanism of Cl− inhibition provided. | ND | [21] |
| Trametes versicolor (crude laccase) | RBBR, Congo red (CR), Malachite green (MG)/NaCl and Na2SO4 | 95 ± 4.0% for MG, 88 ± 3.0% for RBBR, and 75 ± 3.0% for CR/0.5 M salts | Toxicity of all dyes significantly decreased | This work |
Disclaimer/Publisher’s Note: The statements, opinions and data contained in all publications are solely those of the individual author(s) and contributor(s) and not of MDPI and/or the editor(s). MDPI and/or the editor(s) disclaim responsibility for any injury to people or property resulting from any ideas, methods, instructions or products referred to in the content. |
© 2025 by the authors. Licensee MDPI, Basel, Switzerland. This article is an open access article distributed under the terms and conditions of the Creative Commons Attribution (CC BY) license (https://creativecommons.org/licenses/by/4.0/).
Share and Cite
Uber, T.M.; Novi, D.M.P.; Murase, L.Y.; Cheute, V.M.S.; Kagueyama, S.S.; Contato, A.G.; Peralta, R.A.; Bracht, A.; Peralta, R.M. Decolorization and Detoxification of Synthetic Dyes by Trametes versicolor Laccase Under Salt Stress Conditions. Reactions 2025, 6, 53. https://doi.org/10.3390/reactions6040053
Uber TM, Novi DMP, Murase LY, Cheute VMS, Kagueyama SS, Contato AG, Peralta RA, Bracht A, Peralta RM. Decolorization and Detoxification of Synthetic Dyes by Trametes versicolor Laccase Under Salt Stress Conditions. Reactions. 2025; 6(4):53. https://doi.org/10.3390/reactions6040053
Chicago/Turabian StyleUber, Thaís Marques, Danielly Maria Paixão Novi, Luana Yumi Murase, Vinícius Mateus Salvatori Cheute, Samanta Shiraishi Kagueyama, Alex Graça Contato, Rosely Aparecida Peralta, Adelar Bracht, and Rosane Marina Peralta. 2025. "Decolorization and Detoxification of Synthetic Dyes by Trametes versicolor Laccase Under Salt Stress Conditions" Reactions 6, no. 4: 53. https://doi.org/10.3390/reactions6040053
APA StyleUber, T. M., Novi, D. M. P., Murase, L. Y., Cheute, V. M. S., Kagueyama, S. S., Contato, A. G., Peralta, R. A., Bracht, A., & Peralta, R. M. (2025). Decolorization and Detoxification of Synthetic Dyes by Trametes versicolor Laccase Under Salt Stress Conditions. Reactions, 6(4), 53. https://doi.org/10.3390/reactions6040053

